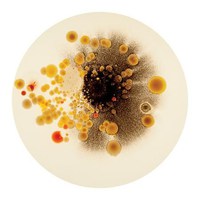
list icon

- ecologia sistêmica
- ▧ revisão - florestas com araucárias (22/9)
- ▧ seminário - recuperação de áreas degradadas (29/11)
- ▧ prova 6/12
- biomonitoramento e ecotoxicologia
- ▧ estudo de caso
- ▧ atividade sobre o capítulo de livro
- ▧ projeto de biorremediação
- biotecnologia
- filmes - discutir bioética 100/100
- ▧ atividade forms 4/10; 96/100
- ▧ prova 18/10; 84/100
- ▧ seminários: biorremediação 100/100
- ▧ prova 6/12 83/100
- legislação ambiental
- ▧ prova 20/10 48/60
- ▧ paper "primavera silenciosa" 39/40
- ▧ segundo paper 2/12 40/40
- ▧ prova 8/12
- biologia reprodutiva
- ▧ prova 29/10 65/100
- ▧ prova 26/11 95/100
aug 10 2021 ∞
dec 25 2021 +